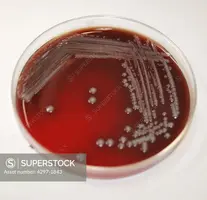
4297-1843.webp

Vaya dia.
Hemos ido al hospital a hacer la ecografia que toca. Todo va muy bien, nos han dicho el sexo de la criatura que esperamos y mucha alegria. Hemos hecho la ronda de llamadas para transmitir las buenas nuevas al inner circle familiar y nos han brindado con el reverso de esta vida. "Te acuerdas de como estaba ya muy mal en semana santa nuestro familiar? Pues hace dos dias hablé con él, ayer se puso muy mal y hoy le han sedado ya para dejarle ir."
Me ha vuelto a escribir a las 20:41 para decirme que ya ha muerto. Las gallinas que entran por las que salen. El ciclo de la vida, la muerte y el tiempo. Y me estoy obsesionado muchísimo con el tiempo. Probablemente por empezar a ser consciente de que he vivido la mitad de mi vida si no pasa nada raro y todo sigue su curso, y como dice esa cancion de Tom Rosenthal, hasta ahora no he estado mas que intentando distraerme de darne cuenta de mi propia mortalidad.
Por ser consciente de que me quedan los últimos años buenos con mis padres antes que la enfermedad se los lleve también, queda poco tiempo y no consigo quitarme esta sensación que empieza a sentirse como una losa, la sensación de estar perdiendo el tiempo. O no aprovecharlo mas bien.
Tampoco ayuda vivir lejos, 12 años ya fuera de casa. Es curioso ver como te vas y evidentemente el tiempo sigue su curso para todos. Las vidas siguen. Cada vez más menos a casa, las amistades también padecen cuando falta el contacto del dia a dia. Ya no estás ahi y la vida a seguido sin ti, poco a poco te has convertido en un recuerdo o quizás ni eso, acabas perdiendo el arraigo de lo que fue CASA y donde quiera que hayas ido a dar con tus huesos tampoco es tu casa, porque la integración nunca llega a ser completa.
Asi que el resultado es estar en tierra de nadie sabiendo que pierdo el tiempo.
No hago más de lo necesario en el trabajo, estoy como para regalar el tiempo a una empresa, ni por todo el dinero del mundo. Tiempo es lo único que me queda en este mundo y quiero aprovecharlo con los mios, porque al final lo único real en esta vida es la muerte, y hacia ella voy con la cabeza bien alta sabiendo que he hecho lo que tenia que hacer.
𝕬 𝖕𝖔𝖗 𝖑𝖆 𝖒𝖚𝖊𝖗𝖙𝖊!
𝕬 𝖕𝖔𝖗 𝖑𝖆 𝖒𝖚𝖊𝖗𝖙𝖊!
 Muerto por dentro
Muerto por dentro